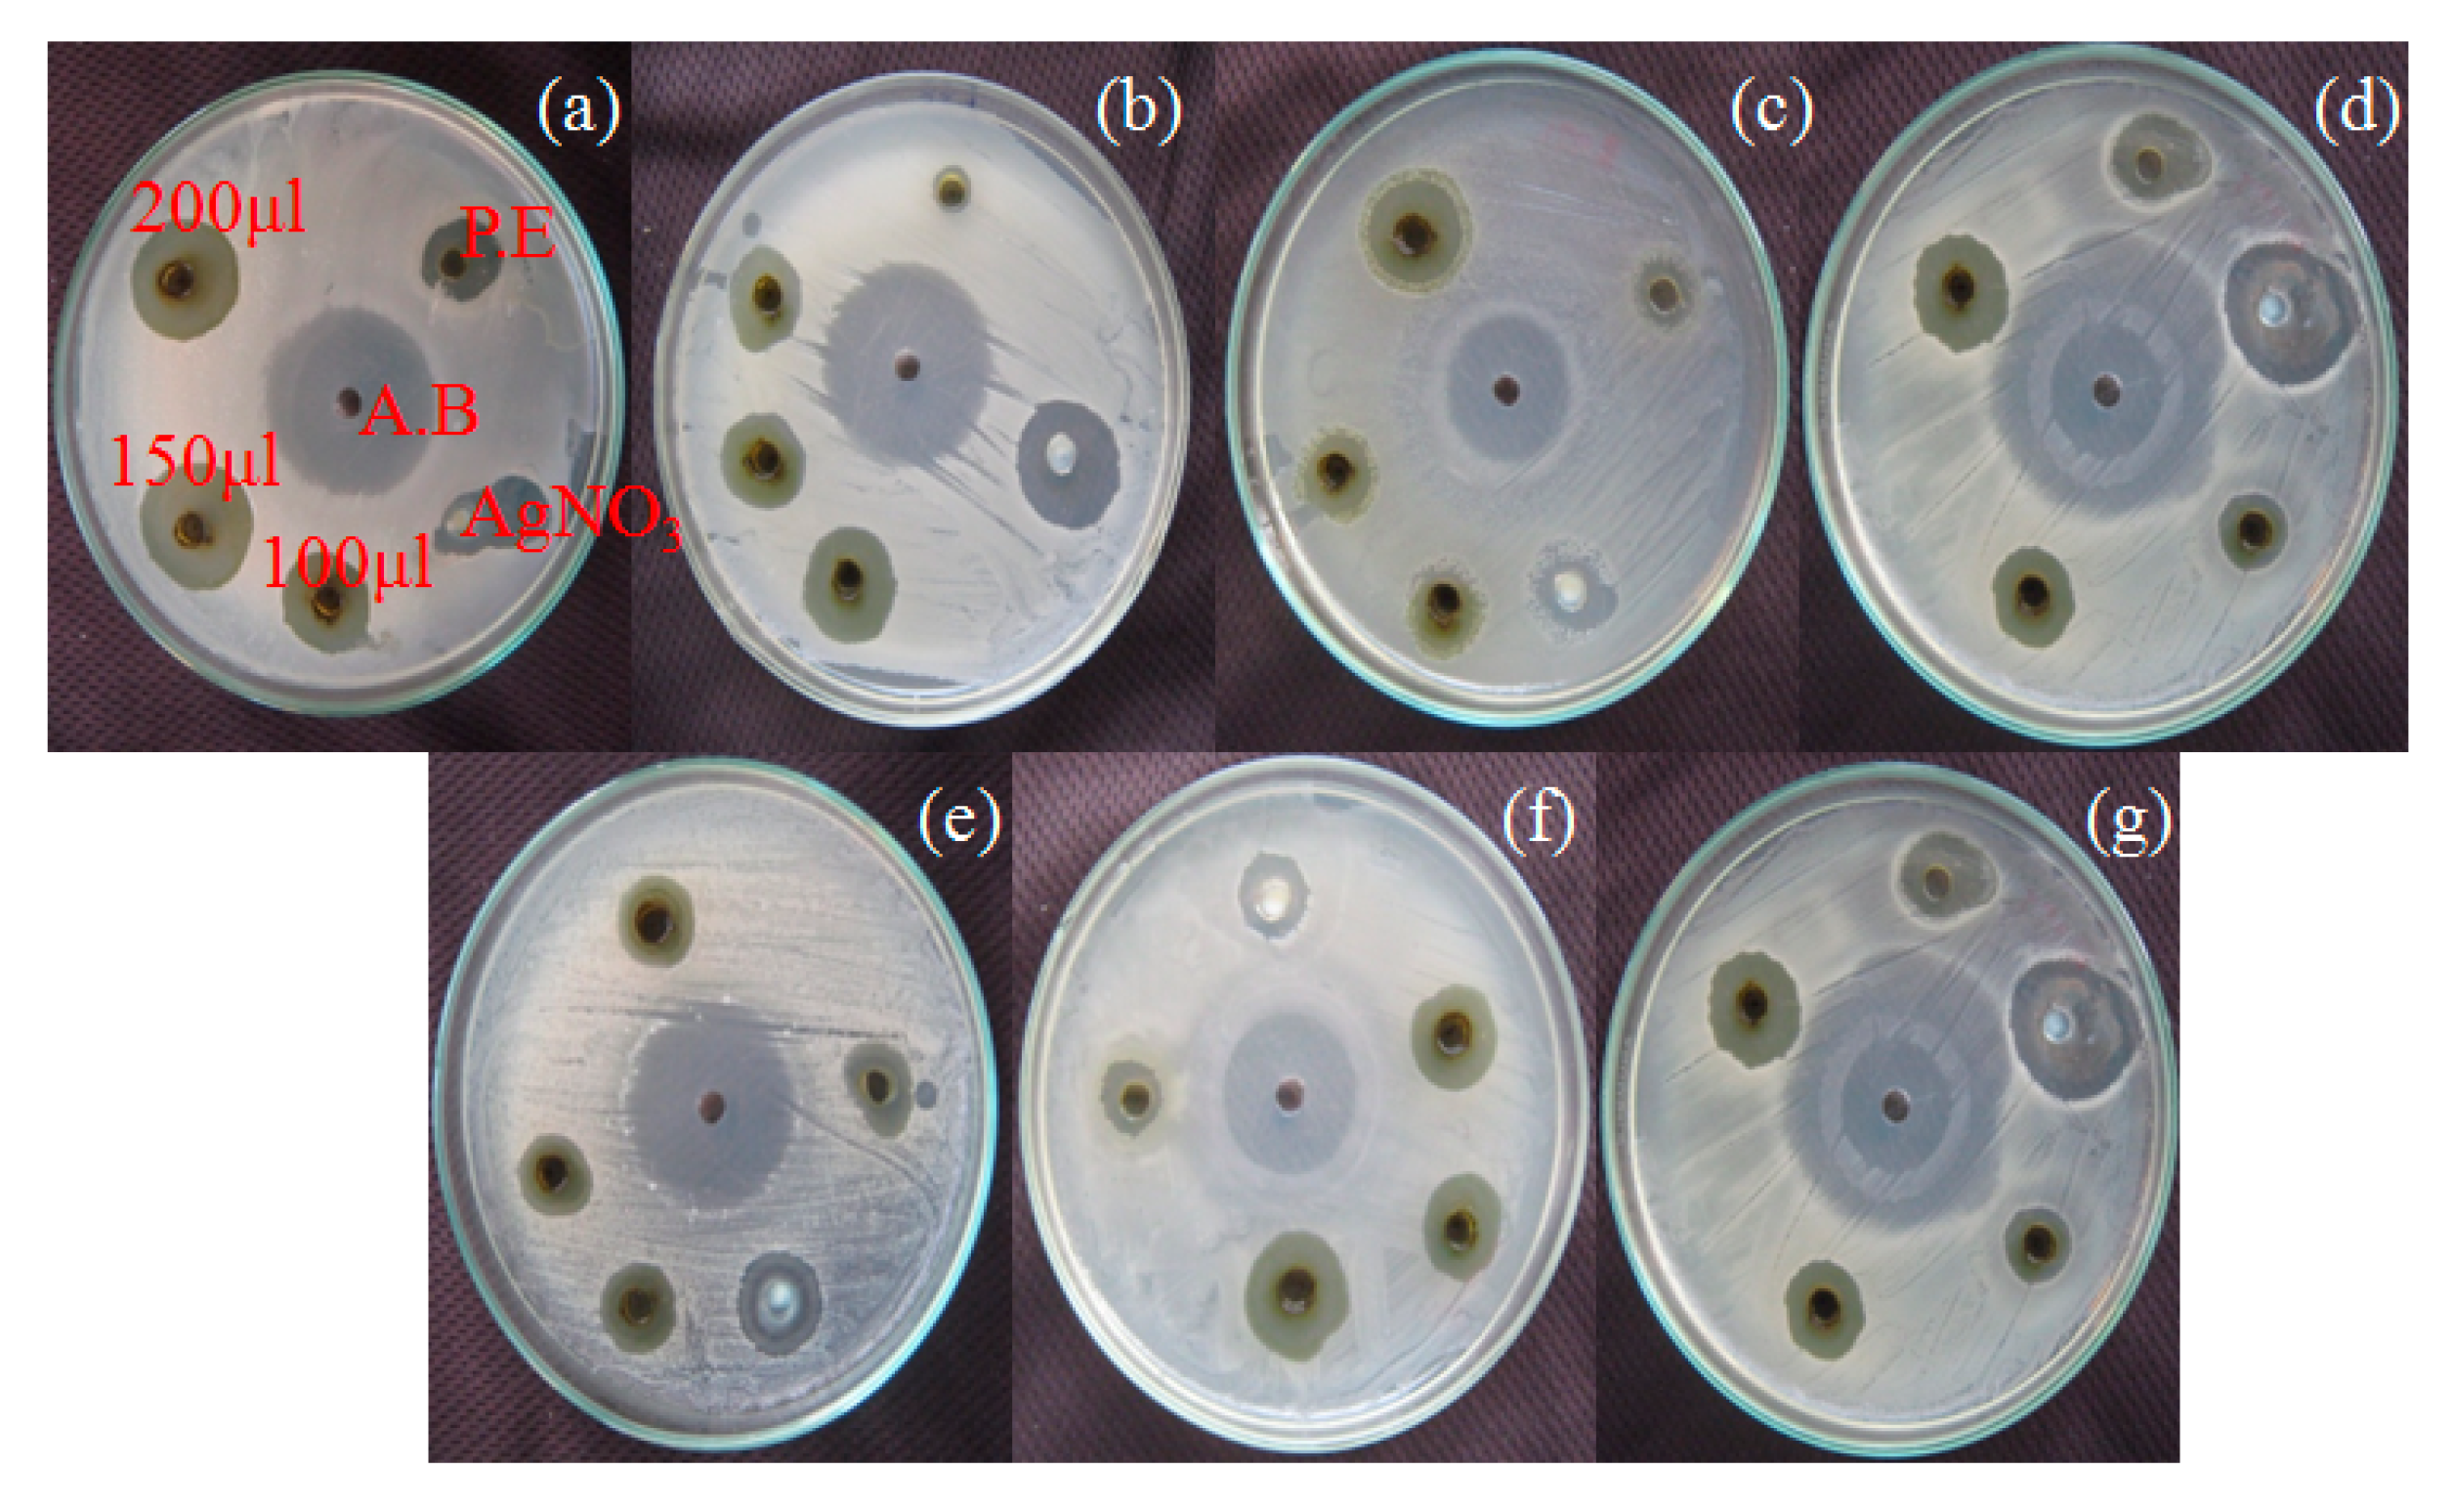
Photochem 01 00016 g011 550

Leaf Extract Arbitrated Biogenic Synthesis of Silver Nanospheres by a Medicinal Plant from the Western Ghats with Enhanced Antimicrobial Property
Abstract
:1. Introduction
2. Materials and Methods
2.1. Preparation of Plant Extract
2.2. Biosynthesis of Silver Nanoparticles
2.3. Characterization
3. Results and Discussion
3.1. UV Absorbance Analysis
3.2. FTIR Analysis
3.3. XRD Analysis
3.4. SEM and EDX Analysis
3.5. TEM Analysis
3.6. Photocatalytic Efficiency of the Ag NPs
3.7. Antimicrobial Activity for Silver Nanoparticles
4. Conclusions
Author Contributions
Funding
Acknowledgments
Conflicts of Interest
References
- Kasthuri, J.; Kathiravan, K.; Rajendiran, N.J. Phyllanthin-assisted biosynthesis of silver and gold nanoparticles: A novel biological approach. Nanoparticle Res. 2009, 11, 1075. [Google Scholar] [CrossRef]
- Narayanan, R.; El-Sayed, M.A. Shape-Dependent Catalytic Activity of Platinum Nanoparticles in Colloidal Solution. Nano Lett. 2004, 4, 1343. [Google Scholar] [CrossRef]
- Gomez-Romero, P. Hybrid Organic–Inorganic Materials—In Search of Synergic Activity. Adv. Mater. 2001, 13, 163. [Google Scholar] [CrossRef]
- Ajitha, B.; Ashok Kumar Reddy, Y.; Sreedhara Reddy, P. Green synthesis and characterization of silver nanoparticles using Lantana camara leaf extract. Mater. Sci. Eng. C 2015, 49, 373. [Google Scholar] [CrossRef]
- Masurkar, S.A.; Chaudhari, P.R.; Shidore, V.B.; Kamble, S.P. Rapid Biosynthesis of Silver Nanoparticles Using Cymbopogan Citratus (Lemongrass) and its Antimicrobial Activity. Nano-Micro Lett. 2011, 3, 189. [Google Scholar] [CrossRef] [Green Version]
- Kouvaris, P.; Delimitis, A.; Zaspalis, V.; Papadopoulos, D.; Sofia, A.T.; Michailidisa, N. Green synthesis and characterization of silver nanoparticles produced using Arbutus Unedo leaf extract. Mater. Lett. 2012, 76, 18. [Google Scholar] [CrossRef] [Green Version]
- Guidelli, E.J.; Ramos, A.P.; Zaniquelli, M.E.D.; Bajja, O. Green synthesis of colloidal silver nanoparticles using natural rubber latex extracted from Hevea brasiliensis. Spectrochim. Acta Part A Mol. Biomol. Spectrosc. 2011, 82, 140. [Google Scholar] [CrossRef] [PubMed]
- Ahmad, N.; Sharma, S. Green Synthesis of Silver Nanoparticles Using Extracts of Ananas comosus. Green Chem. 2012, 2, 141. [Google Scholar]
- Tran, Q.H.; Nguyen, V.Q.; LE, A.T. Corrigendum: Silver nanoparticles: Synthesis, properties, toxicology, applications and perspectives. Adv. Nat. Sci. Nanotechnol. 2013, 4, 033001. [Google Scholar] [CrossRef] [Green Version]
- Jeeva, K.; Thiyagarajan, M.; Elangovan, V.; Geetha, N.; Venkatachalam, P. Caesalpinia coriaria leaf extracts mediated biosynthesis of metallic silver nanoparticles and their antibacterial activity against clinically isolated pathogens. Ind. Crop. Prod. 2014, 52, 714. [Google Scholar] [CrossRef]
- Sharma, V.K.; Yngard, R.A.; Lin, Y. Silver nanoparticles: Green synthesis and their antimicrobial activities. Adv. Colloid Interface Sci. 2009, 145, 83. [Google Scholar] [CrossRef]
- Prasad, K.S.; Pathak, D.; Patel, A.; Dalwadi, P.; Prasad, R.; Patel, P.; Selvaraj, K. Biogenic synthesis of silver nanoparticles using Nicotiana tobaccum leaf extract and study of their antibacterial effect. Afr. J. Biotechnol. 2011, 10, 8122. [Google Scholar]
- Rajeswari, A.; Sujatha, D.; Balasaraswathi, K.; Mani, U.; Chellan, R.; Asit Baran, M. Phytosynthesis of silver nanoparticles using Coccinia grandis leaf extract and its application in the photocatalytic degradation. Colloids Surf. B Biointerfaces 2012, 94, 226. [Google Scholar]
- Jiang, H.; Manolache, S.; Wong, A.C.L.; Denes, F.S. Plasma-enhanced deposition of silver nanoparticles onto polymer and metal surfaces for the generation of antimicrobial characteristics. J. Appl. Polym. Sci. 2004, 93, 1411. [Google Scholar] [CrossRef]
- Prabhu, S.; Poulose, E.K. Silver nanoparticles: Mechanism of antimicrobial action, synthesis, medical applications, and toxicity effects. Int. Nano Lett. 2012, 2, 32. [Google Scholar] [CrossRef] [Green Version]
- Douglas, T.; Young, M. Host–guest encapsulation of materials by assembled virus protein cages. Nature 1998, 393, 152. [Google Scholar] [CrossRef]
- Mourato, A.; Gadanho, M.; Lino, A.R.; Tenriro, R. Biosynthesis of Crystalline Silver and Gold Nanoparticles by Extremophilic Yeasts. Bioinorg. Chem. Appl. 2011, 2011, 546074. [Google Scholar] [CrossRef] [PubMed]
- Nithya, R.; Ragunathan, R. Synthesis of silver nanoparticle using pleurotus sajor caju and its antimicrobial activity study. Dig. J. Nanomater. Biostructures 2009, 4, 623. [Google Scholar]
- Sulaiman, G.M.; Mohammed, W.H.; Marzoog, T.R.; Abdul Amir AlAmiery, A.; Kadhum, A.A.H.; Mohamad, A.B. Green synthesis, antimicrobial and cytotoxic effects of silver nanoparticles using Eucalyptus chapmaniana leaves extract. Asian Pac. J. Trop. Biomed. 2013, 3, 58. [Google Scholar] [CrossRef] [Green Version]
- Li, S.; Shen, Y.; Xie, A.; Yu, X.; Qiu, V.; Zhang, L.; Zhang, Q. Green synthesis of silver nanoparticles using Capsicum annuum L. extract. Green Chem. 2007, 9, 852. [Google Scholar] [CrossRef]
- Noginov, M.A.; Zhu, G.; Bahoura, M.; Adegoke, J.; Smal, C.; Ritzo, B.A.; Drachev, V.P.; Shalaev, V.M. The effect of gain and absorption on surface plasmons in metal nanoparticles. Appl. Phys. B 2007, 86, 455. [Google Scholar] [CrossRef]
- Amarendra, D.D.; Krishna, G. Biosynthesis of silver and gold nanoparticles using Chenopodium album leaf extract. Colloids Surfaces. A Physicochem. Eng. Asp. 2010, 369, 27. [Google Scholar]
- Philip, D. Mangifera Indica leaf-assisted biosynthesis of well-dispersed silver nanoparticles. Spectrochim. Acta Part A Mol. Biomol. Spectrosc. 2011, 78, 327. [Google Scholar] [CrossRef]
- HimakshiBhati, K.; Malik, C.P. Biosynthesis of silver nanoparticles using fresh extracts of Tridax Procumbens Linn. Indian J. Exp. Biol. B 2014, 52, 359. [Google Scholar]
- Garcia, M.A. Surface plasmons in metallic nanoparticles: Fundamentals and applications. J. Phys. D Appl. Phys. 2011, 28, 44. [Google Scholar] [CrossRef]
- Prakash, K.; Vinoth Kumar, J.; Latha, P.; SenthilKumar, P.; Karuthapandian, S. Fruitful fabrication of CDs on GO/g-C3N4 sheets layers: A carbon amalgamation for the remediation of carcinogenic pollutants. J. Photochem. Photobiol. A 2019, 370, 94. [Google Scholar] [CrossRef]
- Vasudeva Reddy, N.; Venkata Subbaiah, K.; Venkateswarlu, N.; Pushpalatha, B.; Sukhendu Bikash, G.; Vijaya, T. First report of biomimetic synthesis of silver nanoparticles using aqueous callus extract of Centella asiatica and their antimicrobial activity. Appl. Nanosci. 2015, 5, 801. [Google Scholar]
- Choi, O.; Hu, Z. Size dependent and reactive oxygen species related nanosilver toxicity to nitrifying bacteria. Environ. Sci. Technol. 2008, 42, 4583. [Google Scholar] [CrossRef]

Publisher’s Note: MDPI stays neutral with regard to jurisdictional claims in published maps and institutional affiliations. |
© 2021 by the authors. Licensee MDPI, Basel, Switzerland. This article is an open access article distributed under the terms and conditions of the Creative Commons Attribution (CC BY) license (https://creativecommons.org/licenses/by/4.0/).
Share and Cite
Sherin, J.; Senthil Kumar, P.; Karuthapandian, S. Leaf Extract Arbitrated Biogenic Synthesis of Silver Nanospheres by a Medicinal Plant from the Western Ghats with Enhanced Antimicrobial Property. Photochem 2021, 1, 264-274. https://doi.org/10.3390/photochem1020016
Sherin J, Senthil Kumar P, Karuthapandian S. Leaf Extract Arbitrated Biogenic Synthesis of Silver Nanospheres by a Medicinal Plant from the Western Ghats with Enhanced Antimicrobial Property. Photochem. 2021; 1(2):264-274. https://doi.org/10.3390/photochem1020016
Chicago/Turabian StyleSherin, John, Puvanesvaran Senthil Kumar, and Swaminathan Karuthapandian. 2021. "Leaf Extract Arbitrated Biogenic Synthesis of Silver Nanospheres by a Medicinal Plant from the Western Ghats with Enhanced Antimicrobial Property" Photochem 1, no. 2: 264-274. https://doi.org/10.3390/photochem1020016
APA StyleSherin, J., Senthil Kumar, P., & Karuthapandian, S. (2021). Leaf Extract Arbitrated Biogenic Synthesis of Silver Nanospheres by a Medicinal Plant from the Western Ghats with Enhanced Antimicrobial Property. Photochem, 1(2), 264-274. https://doi.org/10.3390/photochem1020016

